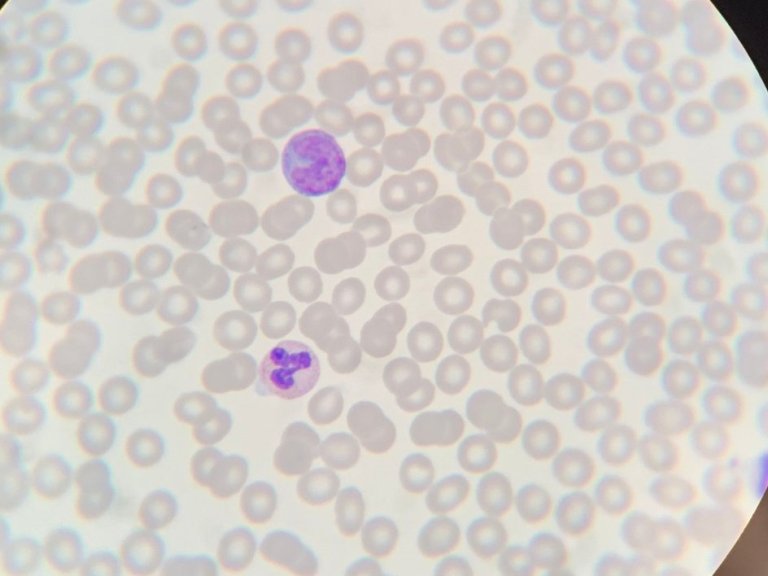
Temporary benefit for immune system in early HIV treatment, but dysregulation returns

The National Academy of Medicine was formed in 1970 in order to tackle "questions of [US] national importance” and its members are not only medical professionals but a full spectrum of academics and expects from disciplines including law, administration, engineering, and the humanities. Current members include WHO Director-General, Tedros Adhanom Ghebreyesus as well as 2020 Anatomische Les laureate and former U.S. Chief Medical Advisor, Anthony Fauci.
Agyemang's nomination noted that he is added to the list of members "for providing novel insight into the effects of global migration on obesity, diabetes and cardiovascular diseases." While also reflecting on the importance of Amsterdam UMC's RODAM study, "Agyemang's team conducted the first comprehensive research on health outcomes in African migrants in Europe, utilizing epidemiological, social, clinical and molecular tools."
Agyemang himself is "very thrilled and delighted to be elected". "This is an excellent recognition of the work my team has been doing over the years in addressing the health needs of migrant populations. I am very grateful to the team and the excellent support from Amsterdam UMC. This is an outstanding achievement not only for me but also for my team and Amsterdam UMC," he adds.
Alongside the RODAM study, Agyemang is also one of the leaders of HELIUS study, which follows the health of 25,000 residents of Amsterdam. HELIUS research has led to publications on diverse topics such as the COVID-19 pandemic and cardiovascular risk factors.
Read more about Agyemang's work in this interview, conducted last year.
About the US National Academy of Medicine
The US National Academy of Medicine was formed in 1970 by the U.S Congress, with the aim of improving "health for all by advancing science, accelerating health equity, and providing independent, authoritative, and trusted advice nationally and globally." Each year no more than 80 members are added to the Academy, with a maximum of 10 foreign experts per year. The New York Times named the Academy as the "most esteemed and authoritative adviser on issues of health and medicine, and its reports can transform medical thinking around the world"
Photo: Dirk Gillissen